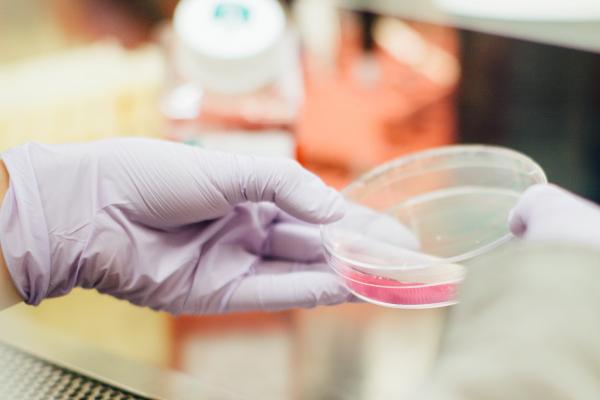

Mae buddsoddiad Llywodraeth Cymru mewn prifysgolion a deallusrwydd artiffisial yn newid bywydau ac yn helpu Cymru i ddod yn arweinydd rhyngwladol yn y maes. Fel rhan o’r Strategaeth Ddigidol i Gymru, mae £500,000 o gyllid yn cael ei rannu rhwng 22 o brosiectau arloesol.
Mae Cyflymydd Cenedl Ddata Cymru yn fenter ar y cyd rhwng Prifysgolion Caerdydd, Abertawe, Aberystwyth a Bangor sy’n helpu Cymru i sicrhau llwyddiant hirdymor yn y maes deallusrwydd artiffisial a gwyddor data.
Wrth i ddeallusrwydd artiffisial a gwyddor data ddod yn fwy cyffredin, mae timau ymchwil y prifysgolion yn helpu pobl ledled Cymru drwy sicrhau bod prosiectau’n symud ymlaen gyda chymorth diwydiant fel bod modd mabwysiadu’r canlyniadau i wella cynaliadwyedd, ansawdd bywyd a chanlyniadau economaidd. Ar yr un pryd, bydd hyn yn helpu i greu gweithlu medrus sydd â chymhwysedd digidol.
Bydd yr Athro Matthias Eberl a’i dîm yn Ysgol Feddygaeth Prifysgol Caerdydd yn defnyddio deallusrwydd artiffisial i helpu atal sepsis mewn cleifion sy’n cael llawdriniaethau ar yr abdomen. Mae cyllid gan Lywodraeth Cymru wedi’u helpu i gydweithio â phartneriaid i gefnogi eu hymchwil.
Gall buddsoddi yn y math hwn o ymchwil helpu i ddatrys heriau sy'n effeithio'n arbennig ar Gymru. Mae Prifysgol Aberystwyth yn cefnogi'r sector amaethyddol drwy ddefnyddio deallusrwydd artiffisial i nodi’n gyflym parasitiaid sy'n gyffredin mewn da byw sy'n pori yng Nghymru oherwydd ein hinsawdd.
Mae Prifysgol Bangor yn cefnogi ein hamgylchedd drwy ddatblygu offer meddalwedd i ddefnyddio technoleg radar ar hyd arfordir Cymru. Bydd hyn yn rhoi gwybodaeth werthfawr, amser real i ddatblygwyr ynni adnewyddadwy morol, porthladdoedd ac awdurdodau lleol am y tonnau a'r cerrynt yn ein dyfroedd arfordirol. Bydd yr ymchwil yn helpu i ddod o hyd i safleoedd gwell ar gyfer ynni adnewyddadwy a gwella diogelwch.
Dywedodd Gweinidog y Gymraeg ac Addysg, Jeremy Miles:
Mae Cymru'n gartref i ymchwil addysg uwch wych. Mae'n dda gweld ein prifysgolion yn cydweithio i sicrhau bod Cymru ar flaen y gad o ran datblygiadau mewn gwyddor data a deallusrwydd artiffisial.
Rwy'n falch bod y cyllid hwn wedi helpu i gefnogi prosiectau sydd â'r pŵer i wella bywydau pobl yma yng Nghymru a thu hwnt.
Mae Cyflymydd Cenedl Ddata Cymru yn enghraifft o sut y gall sector addysg uwch cryf gefnogi pob agwedd ar ein bywydau a sicrhau ein bod yn barod ar gyfer y dyfodol.
Dywedodd Gweinidog yr Economi, Vaughan Gething:
Ni fu ymchwil, gwyddoniaeth a thechnoleg erioed yn bwysicach o ran cefnogi prosiectau a chanlyniadau sy'n canolbwyntio ar atebion i fynd i'r afael â phroblemau byd-eang mawr ein hoes.
Rwy'n hyderus y bydd y cyllid newydd hwn yn cefnogi ein prifysgolion i weithio gyda phartneriaid yn y diwydiant i ddefnyddio'r arloesedd technolegol diweddaraf mewn gwyddor data a deallusrwydd artiffisial i gyflawni hynny.
Wrth wneud hynny, byddant yn helpu i roi hwb i economi Cymru drwy helpu i greu diwydiannau'r dyfodol, a fydd yn creu'r swyddi newydd o ansawdd uchel yr ydym am eu gweld ledled Cymru.
Dywedodd yr Athro Roger Whitaker, Dirprwy Is-ganghellor Etholedig ar gyfer Ymchwil, Arloesi a Menter ym Mhrifysgol Caerdydd:
Mae'r byd yn newid ar gyflymder digynsail oherwydd gwyddor data a deallusrwydd artiffisial. Mae hyn yn effeithio ar bron bob sector yng Nghymru. Mae Prifysgolion Caerdydd, Abertawe, Bangor ac Aberystwyth wedi ffurfio partneriaeth i gychwyn prosiect Cyflymydd Cenedl Ddata Cymru, rhaglen uchelgeisiol o ymchwil, arloesi a hyfforddiant i gefnogi trawsnewid digidol.
Mae cyllid Llywodraeth Cymru ar gyfer prosiectau 'sbrint' tymor byr wedi galluogi partneriaethau â sefydliadau a chwmnïau i ddangos yn gyflym pŵer a photensial data a thechnolegau a yrrir gan ddeallusrwydd artiffisial. Mae hyn yn cefnogi gwell iechyd a lles, gwell gwasanaethau cyhoeddus, economi gystadleuol a phlaned wyrddach.